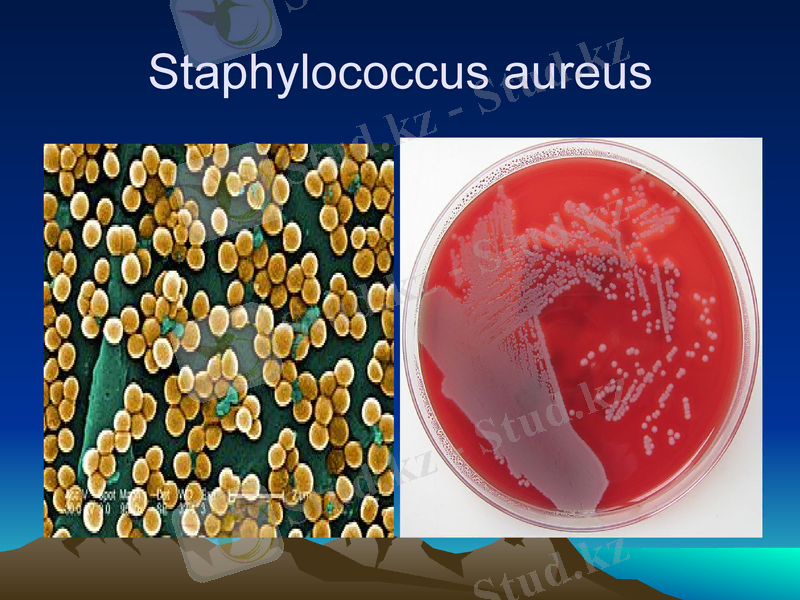
Slide 9

Санитарлық-көрсеткіш микроағзалар және стерилдеу мен залалсыздандыру әдістері



Дәріс№ 10
Тақырыбы:«Санитарлық-көрсеткіш микроағзалар. Стерилдеу мен залалсыздандыру»
Жоспары
1. Санитарлық-көрсеткіш микроағзалар.
2. Стерилдеу түрлері мен оның қолданылуы.
3. Залалсыздандыру әдістері.
4. Залалсыздандырушы құралдар классификациясы.
5. Суды залаласыздандырудың әдістері.

Санитарлық-көрсеткіш микроағзалар - бұл адам немесе жануар ағзасының табиғи қуыстарында тұрақты түрде болатын және сыртқы ортада тіршілік етпейтін микробтар.
Санитарлық-көрсеткіш микроағза ретінде 1885 жылдан бастап ішек таяқшасы қолданылады. Осы кезден бастап, ішек таяқшасының болуы ластану индикаторы болып табылады. Ішек таяқшасының бактериялар тобы энтеробактериялар туыстығына жатады. Осы туыстыққа 5 тұқымдас енеді, олардың арасында Escherichia түрі, ол өзіне санитарлық микробиология үшін қызығушылық тудыратын бірнеше түрді енгізеді:Escherichia coli aerogenes;
Escherichia coli commune;
Escherichia paracoli;
Escherichia coli citrovorum;
Санитарлық-көрсеткіш микроағзалар.

Ең көп жағдайда екінші және үшінші түр кездеседі. Бактериялар өте өзгергіш және сыртқы ортаға түсе отырып, олар өздеріне тән көптеген сипаттарын жоғалтады. Сондықтан санитарлық-көрсеткіштерге ішек таяқшаларының келесі сипаттарға ие барлық түрлері жатады: ұсақ қозғалғыш грамтеріс, таяқша спораларын түзбейтіндер, пішін өзгергіштік, аэробиоз немесе факультативті анаэробиоз, Эндо ортасында қызыл колонияларды түзе отырып өсу және глюкоза мен маннитті 20 сағат бойы 43-45оС температурада қышқыл мен газ түзе отырып ашыту қабілеті

Санитарлық-көрсеткіш микроағзалар
Әдетте олар адам ағзасына зиян келтірмейді, бірақ сәйкес жағдайларда патологиялық үрдіс туғызуы мүмкін. Мұндай микроағзаларды шартты түрде патогенділерге жатқызады.
Санитарлы-көрсеткіш микроағзаларға қойылатын талаптар :
Адамның немесе жануардың табиғи қуыстарында тұрақты түрде тіршілік етуі және сыртқы ортаға көп мөлшерде бөлінуі тиіс;
санитарлы-көрсеткіш микроағзалардың сыртқы ортада тіршілік етуінің ұзақтығы, сәйкес патогенді микробтарға қарағанда дәл сондай немесе сәл жоғары болуы қажет;
патогенді микроағзаларға қарағанда, сыртқы ортаның физикалық және химиялық факторларының әсеріне тұрақты болуы керек;
сыртқы ортада көбеймеуі тиіс;
сыртқы орта нысандарынан қарапайым түрде бөлінуі тиіс. Сапрофиттермен басылмауы қажет;
сыртқы ортаға түскен кезде өздерінің биологиялық қасиеттерін дереу өзгертпеуі тиіс.
.

Сыртқы орта объектілерінің санитарлық-гигиеналық жағдайын жанама микробиологиялық көрсеткіштермен анықтайды, ол көрсеткіштер бойынша олардың патогенді микробтармен мүмкін болатын тұқымдану туралы шешім шығаруға болады.
Жалпы микробтық тұқымдану - жалпы микробтық сан (ЖМС) .
Жалпы микробтық сан бұл 1г, 1мл, 1м3 көлем бірлігіндегі микробтардың мөлшері.
Нысанның микробтық тұқымдануын титр немесе индекс түрінде көрсетеді.
Титр - бұл микроағза анықталған зерттеліп жатқан субстраттың ең аз мөлшері.
Индекс - зерттеліп жатқан субстраттың белгілі бір көлемінде анықталатын, мысалы 1000 мл суда, 1 г топырақта, 1 г азық-түлік өнімдерінде ізделіп жатқан микроағза жасушаларының саны. Титрді индекске және кері есептеуді келесідей жүзеге асырады:
Титр = 1000 индекс =1000
Индекс титр
Титр= 1 индекс = 1
Индекс титр
. Сыртқы орта нысандарын санитарлы-гигиеналық бағалаудың микробиологиялық көрсеткіштер

Тыныс алу жолдарының жоғарғы бөлігінің шырышты қабатының тұрақты тіршілік иелері:
Streptococcus viridans жасыл түске бояйтын стрептококк
Гемолитті стрептококк Streptococcus haemolyticus
Іріңді немесе алтын түстес стафилококк (aureus)
Аталған микроағзалар санитарлы-көрсеткіш микроағзалар ретінде қабылданған.

Streptococcus viridans

Streptococcus haemolyticus
Staphylococcus aureus

Стерилдеу.
Стерилдеу - микробиологиялық тәжірибедегі ең маңызды және қажетті тәсілдердің бірі. «Стерилдеу» сөзі латын тілінен аударғанда ұрықсыздандыру деген мағынаны білдіреді. Практикалық жұмыста стерилдеу ретінде, стерилденуші нысанның сыртындағы да, ішіндегі де тіршілік иелерінің барлық формаларын жою үшін қолданылатын әдістер, микробиологтар қоректік орталарды, ыдысты, әртүрлі құралдар мен басқа да қажетті аспаптарды зерттеліп жатқан мәдениеттерде бөгде микроағзалардың жетілуін болдырмау мақсатында стерилдейді. «Стерильдік» термині абсолютті мағынаға ие. Стерилдеудің әдістерІ: Термиялық және салқын стерилдеуді ажыратады. Микробиологияда термиялық стерилдеудің келесідей жалында қыздыру мен күйдіру, құрғақыстық стерилдеу (ыстық ауамен), қысыммен қаныққае бумен стерилдеу (автоклавтау, стерилдеу), бөлшекті стерилдей (тиндализация), қайнату, салқын стерилдеу әдістерінен микробиологтар фильтрлеумен, ультракүлгін сәулелермен және газтәрізді құралдармен стерилдеуді пайдаланады.

Қысымда қаныққан бумен стерилдеу (автоклавтау)
Бұл қоректік орталарды стерилдеудің ең сенімді және ең жиі қолданылатын әдісі. Ол материалды атмосфералықтан жоғары қысымда қаныққан су буымен қыздыруға негізделген. Бу температурасы оның қысымы артқын сайын жоғарылайтыны белгілі. Көптеген микроағзалардың споралары 121°-де қаныққан будың тіпті 5-минуттық экспозициясына шыдамайтындығы анықталған. Тек кейбір топырақ микробтарының споралары ғана 1 атм қысымда тек қана 20 минуттан соң тіршілігін тоқтатады. Бумен стерилдеуді қысымда арнайы герметикалық жабылатын қалыңқабырғалы аппараттар - автоклавтарда жүргізеді.
Компактный переносной автоклав

Бөлшекті стерилдеу (тиндализация)
Бөлшекті стерилдеу, 100°С температурадан жоғары болатын әсер етулерде жойылатын орталарды залалсыздандыру үшін қолданылады. Бұл тәсіл ағылшын ғалымы Тиндальмен енгізілді. Тиндализация ұстанымы, ортаны және оның компоненттерін артық қысымсыз бірнеше рет қыздыратындығына, және қыздырулар арасында тіршілікке ие споралардың өсуіне мүмкіндік беретіндігіне негізделеді. Споралардан дамитын жасушалар келесі қыздырған кезде жаңа споралар түзіп үлгермей, тіршілік жоятындығы болжанады. Қыздыруды қайнаған судың буларында жүзеге асыруға болады, яғни 100 °С температурада немесе аталмыш ағынды бу көмегімен. Ағынды бумен өңдеуді қақпағы ашық автоклавта, Кох қайнатқышында немесе жақсылап бекітілген қақпағы бар су моншасында 20-40 мин бойы 3-4 рет жүргізеді. Қыздыру уақыты будың белсенді түрде бөліну сәтінен бастап белгіленеді.

Фильтрлеумен стерилдеу
Фильтрлеумен стерилдеу микробиологиялық практикада кеңінен қолданылады. Ол қыздыруға шыдамайтын, мысалы, құрамына термолабильді белоктар енетін сұйық және ерітінділер үшін, витаминдер, қанттар, кейбір антибиотиктер, сондай-ақ сарысулар үшін, ұшқыш заттар үшін, мысалы кейбір көмірсутектер және басқалары субстраттар үшін қолданылады. Осындай әдіспен мәдени сұйықтықты ондағы алмасу өнімдерінің өзгеріссіз түрде қалуын қамтамасыз ету үшін микроағзалардың жасушаларынан босатады.
Бактериалды
фильтр

Дезинфекция
Дезинфекция- шикізатқа, суға, жартылай өнімдерге және кәсіпорындардан түсетін зиянды және бөгде микроағзалардың тіршілігін жою мен басу. Дезинфекцияны микроағзалардың вегетативті жасушаларын жою үшін, ал бүкіл спораларды жою үшін әдетте стерилдеуді қолданады.
Микроағзалардың көбеюін тоқтататын және тіршілігін жоятын химиялық заттар антисептиктер деп аталады. Антисептиктер мен дезинфекторларды ажыратады, олар әртүрлі концентрацияларда қолданылатын бірдей заттар болуы мүмкін.

Антисептиктер мен дезинфекторлардың айырмашылықтары
Антисептиктер
Дезинфекторлар
Бактерицидті әсері латентті кезеңнен кейін, 3 және одан да көп сағат өңдеуден соң орын алады
Бактерицидті әсері бактериялармен әрекеттескен соң бірден жүзеге асады.
Құрамына органикалық заттар енетін орталарда белсендірек.
Органикалық заттар жетіспейтін орталарда белсендірек.
Микробты мәдениеттің белсенді даму фазасы аяқталған соң, тіпті үлкен мөлшерлерде белсенді емес.
Микробты мәдениет дамуының кез-келген кезеңінде бактерицидті әсер етеді.
Вегетативті формаларға қатысты белсенді болып табылады.
Споралар мен вегетативті формаларға қатысты белсенді болып табылады.
Беттік керілудің кемуі әруақытта бактерицидті әсерді күшейтпейді.
Беттік керілудің бактерицидті әсерді күшейтеді.
Микроағзалардың тұрақты формалары қалыптасуы мүмкін.
Микроағзалардың тұрақты формаларының қалыптасуын болдырмайды.

Обработка инструментов (дезинфекция)

Дезинфекция әдістері.
Агенттің әсер ету түрі бойынша әдістерді физикалық, химиялық және биологиялық деп бөледі.
Физикалық әдістер: қыздыру (буландыру, қайнату), ұрықсыздандырушы фильтрация, ультрадыбыс пен изотоптардың әсері.
Химиялық әдістер ангтисептиктер мен дезинфекторларды қолдануға негізделеді.
Дезинфекциялаушы заттарды қолданудың жалпы ережелері:
Дезинфициялаушы заттарды қолдану алдында, жабдықтарды мұқият тазалап, онда өндірістік сұйықтықтар мен қалмауын қадалау керек.
Дезинфекциядан кейін, өңделген жабдықтарды сумен мұқият жуу немесе дезинфектанттардың толық жойылуына дейін буландыру қажет.
Жаңадан даярланған дезинфициялаушы ерітінділерді пайдаланған жөн.
Дезинфекцияны талап ететін нысанға тәуелді белгілі бір дезинфекциялаушы затты қолданады.

Минималды концентрациялардағы қарқынды әсері;
Суда ерігіштігі;
Шамалы экспозиция кезіндені әсердің эффективтілігі;
Иіс пен дәмнің болмауы;
Адам ағзасына уытты әсерінің болмауы;
Жабдықтама материалына коррозиялаушы әсердің болмауы;
Дезинфициялаушы заттарға талаптар:

Дезинфекциялаушы заттардың классификациясы
1. Қышқылдар, тұздар мен сілтілердің ерітінділері. Ең жиі түрде 0, 1% каустикалық сода ерітіндісін (NaOH), 1% кальцийлендірілген сода ерітіндісін (Na2CO3) және ізбес сүтін (Ca) қолданады.
2. Галогендер мен олардың туындылары. Олардың арасынан газ түріндегі хлорды, гипохлориттерді, хлор ізбесін, хлораминді пайдаланады.
3. Ауыр металлдардың тұздары. Сынаптың, күмістің, мыстың тұздарын органикалық және бейорганикалық қосылыстары түрінде қолданады. Бұл заттар негізінен микроағзалардың белоктарына коагуляциялаушы әсер етеді. Фенол мен оның туындылары коагуляциялаушы әсер және кейде еріткіш әсер етеді.
4. Төртіншілік аммонийлі тұздар - бактериалды жасушалар (катапиннің) еруін тудыратын қосылыстар.
5. Газотәрізді заттар (күкіртті ангидрид, этилен тотығы) .

Биологиялық әдістер
Биологиялық әдістер антибиотиктерді қолдануға негізделген: продуценттер актиномицеттер, зең саңырауқұлақтары мен бактериялар.
Антибиотиктік белсенділікті анықтау әдістері. Анализдеуші ортасы бар Петри тостағанына антибиотик продуцентінің сызығымен егуді жүргізеді. Осы екпе перпендикуляр, белгілі бір микроағзалар тобының тест-мәдениеттерін егеді (грам-оң, грам-теріс, зеңдер, ашытқылар) . Бұл екпелерді мәдениеттендіріп, тест-мәдениеттердің өсу дәрежесін және олардың антибиотиктер бөлінуіне әсерін бақылайды.
.

Зең саңырауқұлақтар

- Іс жүргізу
- Автоматтандыру, Техника
- Алғашқы әскери дайындық
- Астрономия
- Ауыл шаруашылығы
- Банк ісі
- Бизнесті бағалау
- Биология
- Бухгалтерлік іс
- Валеология
- Ветеринария
- География
- Геология, Геофизика, Геодезия
- Дін
- Ет, сүт, шарап өнімдері
- Жалпы тарих
- Жер кадастрі, Жылжымайтын мүлік
- Журналистика
- Информатика
- Кеден ісі
- Маркетинг
- Математика, Геометрия
- Медицина
- Мемлекеттік басқару
- Менеджмент
- Мұнай, Газ
- Мұрағат ісі
- Мәдениеттану
- ОБЖ (Основы безопасности жизнедеятельности)
- Педагогика
- Полиграфия
- Психология
- Салық
- Саясаттану
- Сақтандыру
- Сертификаттау, стандарттау
- Социология, Демография
- Спорт
- Статистика
- Тілтану, Филология
- Тарихи тұлғалар
- Тау-кен ісі
- Транспорт
- Туризм
- Физика
- Философия
- Халықаралық қатынастар
- Химия
- Экология, Қоршаған ортаны қорғау
- Экономика
- Экономикалық география
- Электротехника
- Қазақстан тарихы
- Қаржы
- Құрылыс
- Құқық, Криминалистика
- Әдебиет
- Өнер, музыка
- Өнеркәсіп, Өндіріс
Қазақ тілінде жазылған рефераттар, курстық жұмыстар, дипломдық жұмыстар бойынша біздің қор #1 болып табылады.



Ақпарат
Қосымша
Email: info@stud.kz